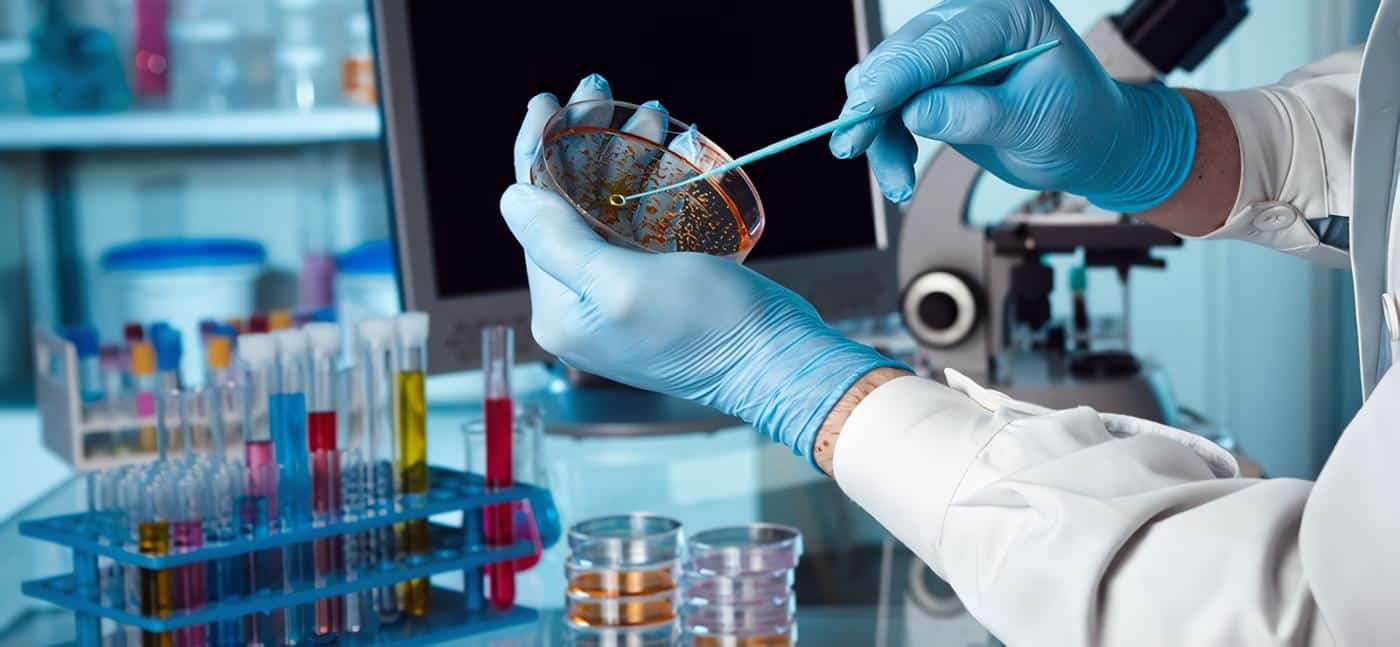

Definición de los ambientes anaeróbico y aeróbico:
Para comenzar debemos definir en qué consisten los ambientes anaeróbicos y aeróbicos. Un ambiente anaeróbico es aquel en el que no hay presencia de oxígeno. En este tipo de ambiente, los organismos que viven allí obtienen energía mediante procesos de fermentación y respiración anaeróbica, que no requieren oxígeno.
Por otro lado, un ambiente aeróbico es aquel en el que sí hay presencia de oxígeno. En este tipo de ambiente, los organismos utilizan el oxígeno para llevar a cabo la respiración aeróbica, que es un proceso más eficiente y produce más energía que la respiración anaeróbica.
Diferencias entre el ambiente anaeróbico y aeróbico
La principal diferencia entre un ambiente anaeróbico y uno aeróbico es la presencia o ausencia de oxígeno. En un ambiente anaeróbico, los organismos no pueden utilizar el oxígeno para obtener energía, lo que limita su capacidad para sobrevivir y realizar funciones vitales.
En contraste, en un ambiente aeróbico, los organismos pueden aprovechar el oxígeno para llevar a cabo la respiración aeróbica, que es un proceso más eficiente para obtener energía. Además, el ambiente aeróbico permite la supervivencia de una mayor variedad de organismos debido a la mayor disponibilidad de oxígeno.
Usos y aplicaciones del ambiente anaeróbico y aeróbico
Un ejemplo de uso del ambiente anaeróbico es la producción de biogás a partir de residuos orgánicos mediante la digestión anaerobia. Este proceso convierte la materia orgánica en biogás compuesto principalmente de metano y dióxido de carbono. El biogás puede utilizarse como fuente de energía en la generación de electricidad y calor.
Por otro lado, el ambiente aeróbico es utilizado en procesos como el tratamiento de aguas residuales. En este proceso, se utiliza aire para que las bacterias aeróbicas descompongan y eliminen los contaminantes presentes en el agua. También se utiliza en la producción de compost, en el que los microorganismos aeróbicos descomponen los materiales orgánicos para producir un abono natural.
Beneficios para el medio ambiente
Tanto el ambiente anaeróbico como el aeróbico tienen beneficios para el medio ambiente. Por ejemplo, el uso de la digestión anaerobia para la producción de biogás a partir de residuos orgánicos reduce la cantidad de residuos que terminan en los vertederos, lo que disminuye las emisiones de gases de efecto invernadero.
Por otro lado, el tratamiento de aguas residuales mediante procesos aeróbicos y anaeróbicos ayuda a prevenir la contaminación del agua, lo que beneficia a los ecosistemas acuáticos y a la salud humana. Además, la producción de compost a partir de materia orgánica reduce la necesidad de fertilizantes químicos, lo que disminuye la contaminación del suelo y del agua.
Más detalles sobre la respiración aeróbica y anaeróbica

La respiración aeróbica es un proceso bioquímico que se produce en presencia de oxígeno, en el cual los organismos utilizan el oxígeno para descomponer la glucosa y otros nutrientes en dióxido de carbono, agua y energía. Este proceso es más eficiente que la respiración anaeróbica, ya que produce más energía por molécula de glucosa.
La respiración anaeróbica, por otro lado, es un proceso bioquímico que se produce en ausencia de oxígeno, en el cual los organismos utilizan otras sustancias como el nitrato, el sulfato, el hierro o el carbonato como aceptores finales de electrones. Este proceso es menos eficiente que la respiración aeróbica, ya que produce menos energía por molécula de glucosa.
Ejemplos de ambientes anaeróbicos y aeróbicos
Un ejemplo de ambientes anaeróbicos es el interior de un vertedero, donde la materia orgánica se descompone en ausencia de oxígeno para producir metano, un gas que contribuye al efecto invernadero. Otro ejemplo es el tracto intestinal de los animales, donde los microorganismos descomponen los alimentos sin oxígeno.
En contraste, un ejemplo de ambientes aeróbicos es el suelo fértil, donde los microorganismos utilizan el oxígeno para descomponer la materia orgánica y liberar nutrientes que las plantas pueden utilizar para crecer. Otro ejemplo es el océano, donde la fotosíntesis de las algas produce oxígeno y los organismos marinos utilizan ese oxígeno para llevar a cabo la respiración aeróbica.
Referencias:
- Jones, O. A., & Voulvoulis, N. (2013). Anaerobic digestion of organic wastes in Europe: status, prospects and policy. Renewable and sustainable energy reviews, 28, 67-80.
- Maillard, É., & Angers, D. A. (2014). Soil aggregate stability and methods for its assessment: a review. Soil biology and biochemistry, 68, 1-12.
- Falkowski, P. G., & Raven, J. A. (2013). Aquatic photosynthesis. Princeton University Press.
- Pongrácz, E., & Kovács, K. L. (2016). Anaerobic digestion of biomass: opportunities, challenges, and emerging directions. In Biomass as a sustainable energy source for the future (pp. 65-90). Springer, Cham.